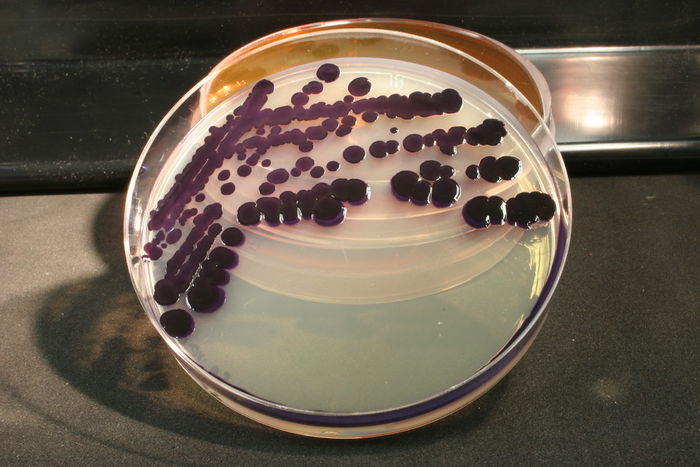

Optimasi Produksi Pewarna Alami Violacein dan Deoxyviolacein pada Bakteri Janthinobacterium
Bakteri dapat menghasilkan pigmen alami yang dapat digunakan sebagai pewarna pada industri makanan, kosmetik, dan tekstil. Salah satu pewarna alami yang dihasilkan oleh beberapa jenis










